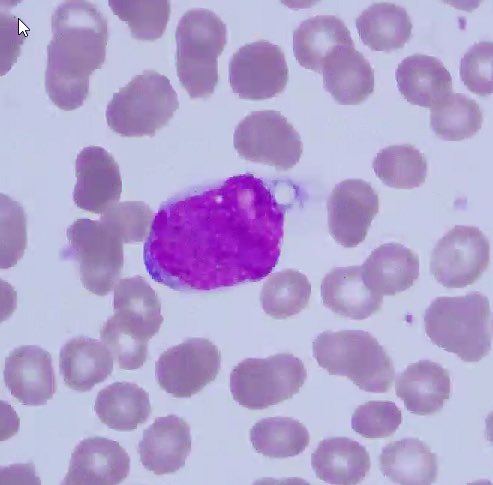
First #LJMFridayUnkowns of the new academic year bringing U a mantle cell lymphoma in spleen. Stains: CD5 &amp; cyclin D1.  This case was TP53-mut remember not all “leukemic, non-nodal” mantle cell lymphomas R indolent (despite what the name implies). Genetics 🧬 matter.. #hemepath

Arantza Onaindia, MD, PhD
@arantzaonaindia
Hospital Universitario Araba (Vitoria-Gasteiz) #Hemepath #Dermpath
ID: 871404137895739394
04-06-2017 16:31:51
56 Tweet
148 Followers
155 Following


Hola a tod@s! Viernes 4 de diciembre en Pathologists Online el Dr. Fernando Pinedo, Jefe AP en Fundación Alcorcón presenta Erupciones cutáneas medicamentosas. Para verlo suscribíos en pathologists-online8.webnode.es o mándanos un email a [email protected]



Do you want to know whats new in Soft tissue tumors? #virtualpathology2020 #BSTpath Great session with Enrique de Álava


Confused by myxoid tumors? Then check out this myxoid review article by me & Nicole D. Riddle, MD, MSHI, FCAP (she/her). Download free here: buff.ly/2Gi1iSR. See also my myxoid video playlist: youtube.com/watch?v=Nn44HW… #pathology #dermpath #BSTpath


We are excited to announce our latest #research!! Is #GATA3 helpful in the diffdx of transformed mycosis fungoides and primary cutaneous CD30-positive T cell LPD? Published in Virchows Archiv (Springer Nature) Congrats to all 🥳🎊 Read the full text here: rdcu.be/cftYt


Hey #hemepath and #erythroid enthusiasts, join us this coming Thursday (Feb 25th) at 8:30pm ET for discussion on role of p53 in erythroid proliferations, moderated by Aadil Ahmed عادل احمد (He/Him). Full text link link.springer.com/article/10.100…. Also check out our new branding :)




Para celebrar los 4000 seguidores, sorteamos gracias a Motic Europe Pathology Division una cámara Moticam X3 Plus, adaptable al ocular del microscopio, entre los socios que sigáis SEAP-IAP, Rev Esp Patol, Motic Europe Pathology Division y realicéis RT a este post hasta el (19/3 inc). Bases: seap.es/actualidad/-/a…




Ever wonder what EBV is up to besides EBER? Please check out our review lead by Emad Ababneh on EBV's effect on host cell metabolism, microenvironment and tumor mutational burden! Also highlighting advances from Johns Hopkins Pathology, Ethel Cesarman & Ben Gewurz lab! onlinelibrary.wiley.com/doi/10.1111/hi…




⏰Last 48h to register to our 1st Hemato MDPI #webinar and discover the latest progress in "Lymphomas and #Hematological #Neoplasia". 👨🏻🎓Chair: Prof. Dr. Antonino Carbone 📅When? #January12 2022, 3:00pm CET 🔗Register by visiting hemato-1.sciforum.net #Lymphoma #Hematology


Actualización en la clasificación de las neoplasias hematolinfoides. #SEAP2023S Santiago Montes Moreno Lluís Colomo juanfer #mariarozman


Actualización en las clasificaciones de llos linfomas T. Un placer haber participado. #SEAP2023S #arantzaonandia #máximofraga #mariarodriguez-pinilla #hemepath Bellvitge Pathology Fundación Jiménez Díaz Hospital Universitari Bellvitge | HUB